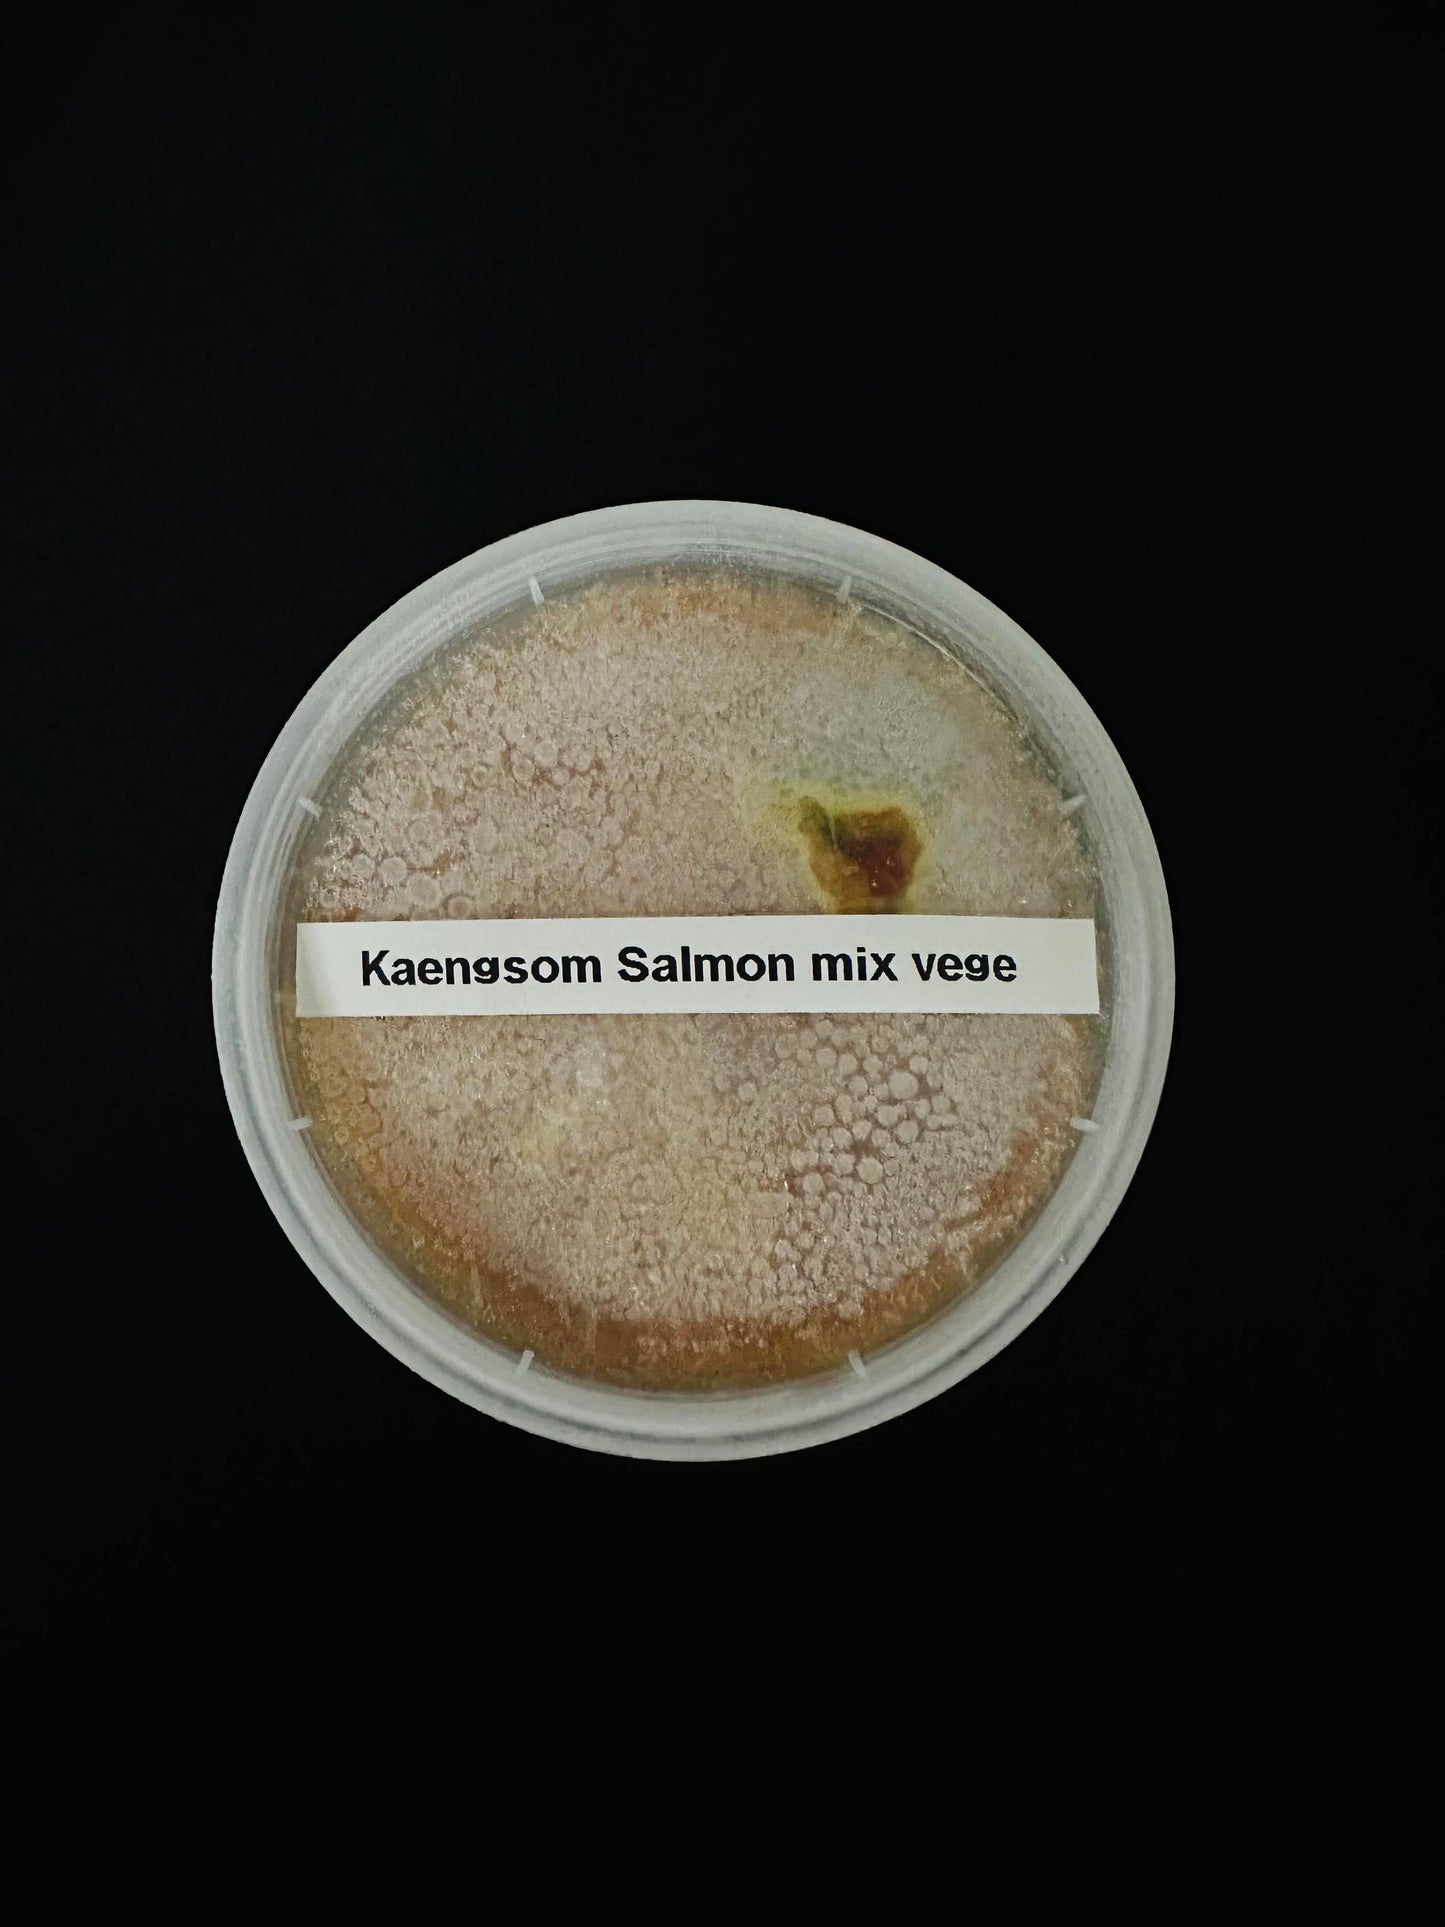
Kaangsom pla salmon pak ruam🌶️ 🌶️ 🌶️ 🌶️

Roynee
Kaangsom pla salmon pak ruam🌶️ 🌶️ 🌶️ 🌶️
Kaangsom pla salmon pak ruam🌶️ 🌶️ 🌶️ 🌶️
Couldn't load pickup availability
Kaangsom Pla Salmon Pak Ruam - Southern Thailand
The recipe for Kaangsom Pla Salmon Pak Ruam holds a special place in our family's collection of cherished recipes. Passed down through generations, this delightful dish showcases the unique flavors and culinary traditions that have been treasured and perfected within our family.
With each bite, you can taste the love and heritage that goes into creating this harmonious combination of salmon, mixed vegetables, and aromatic curry. It is a dish that brings people together, creating lasting memories and a connection to our culinary roots.
Recommendation: Eat with steamed jasmin rice
Falang spicy level: 4/4
Thai spicy level: 4/4
Format: Frozen, 1000ml, rice not included!